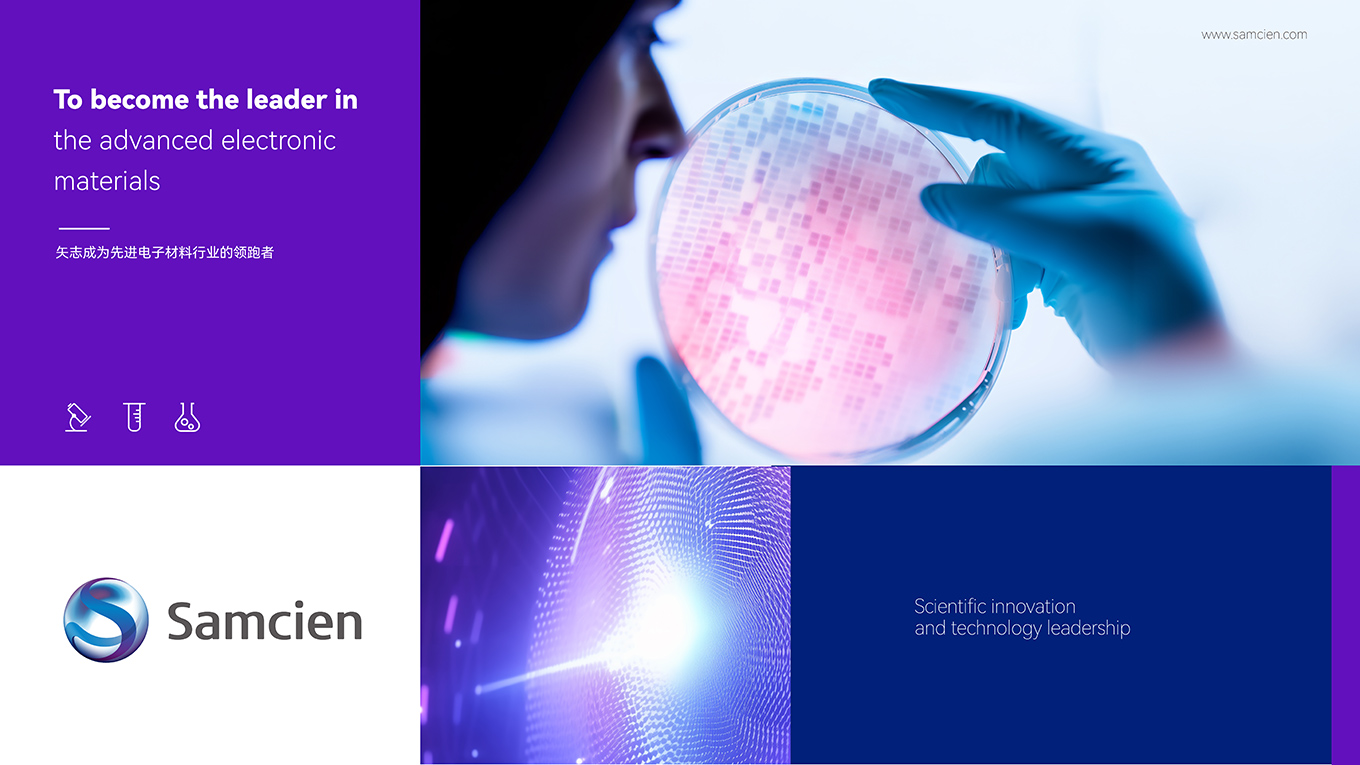
20250508_114629_250.jpg

HX半導(dǎo)體材料和設(shè)備
客戶名稱 : 合訊
服務(wù)內(nèi)容 : VI設(shè)計(jì)、標(biāo)志設(shè)計(jì)、網(wǎng)站設(shè)計(jì)、畫冊設(shè)計(jì)
化訊半導(dǎo)體材料有限公司由中國科學(xué)院深圳先進(jìn)技術(shù)研究院和化訊應(yīng)用材料有限公司共同組建,專注于晶圓級先進(jìn)封裝關(guān)鍵材料的研發(fā)、生產(chǎn)和銷售。公司以集成電路的輕薄短小為導(dǎo)向,重點(diǎn)針對臨時(shí)鍵合、扇出型封裝、硅通孔等關(guān)鍵制程,提供系統(tǒng)解決方案及材料。本次合作,uci聯(lián)合創(chuàng)智為化訊半導(dǎo)體提供了科技公司商標(biāo)設(shè)計(jì)。

做品牌直接找總監(jiān)談
總監(jiān)一對一免費(fèi)咨詢與評估

點(diǎn)擊咨詢總監(jiān)









